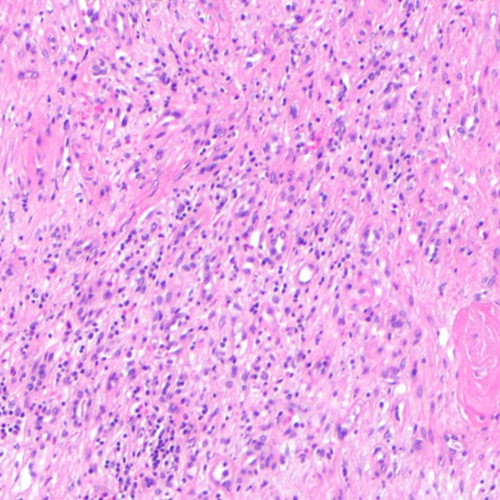

Key points from article :
Elderly who regularly consume walnuts may have lower risk of heart disease.
Meta-analysis of 19 prospective studies was done.
Walnut consumption revealed inverse associations with CVD.
Nuts lower cholesterol and affect endothelial function.
But these effects cannot fully account for the lower CVD outcomes.
Mechanism linking nut consumption to reduced CVD might be diminished inflammation.
“Walnuts have...omega-3 alpha-linolenic acid and other highly bioactive components like polyphenols, that likely play a role in their anti-inflammatory effect..” - Dr.Ros, researcher.
Research by IDIBAPS published in Journal of the American College of Cardiology,